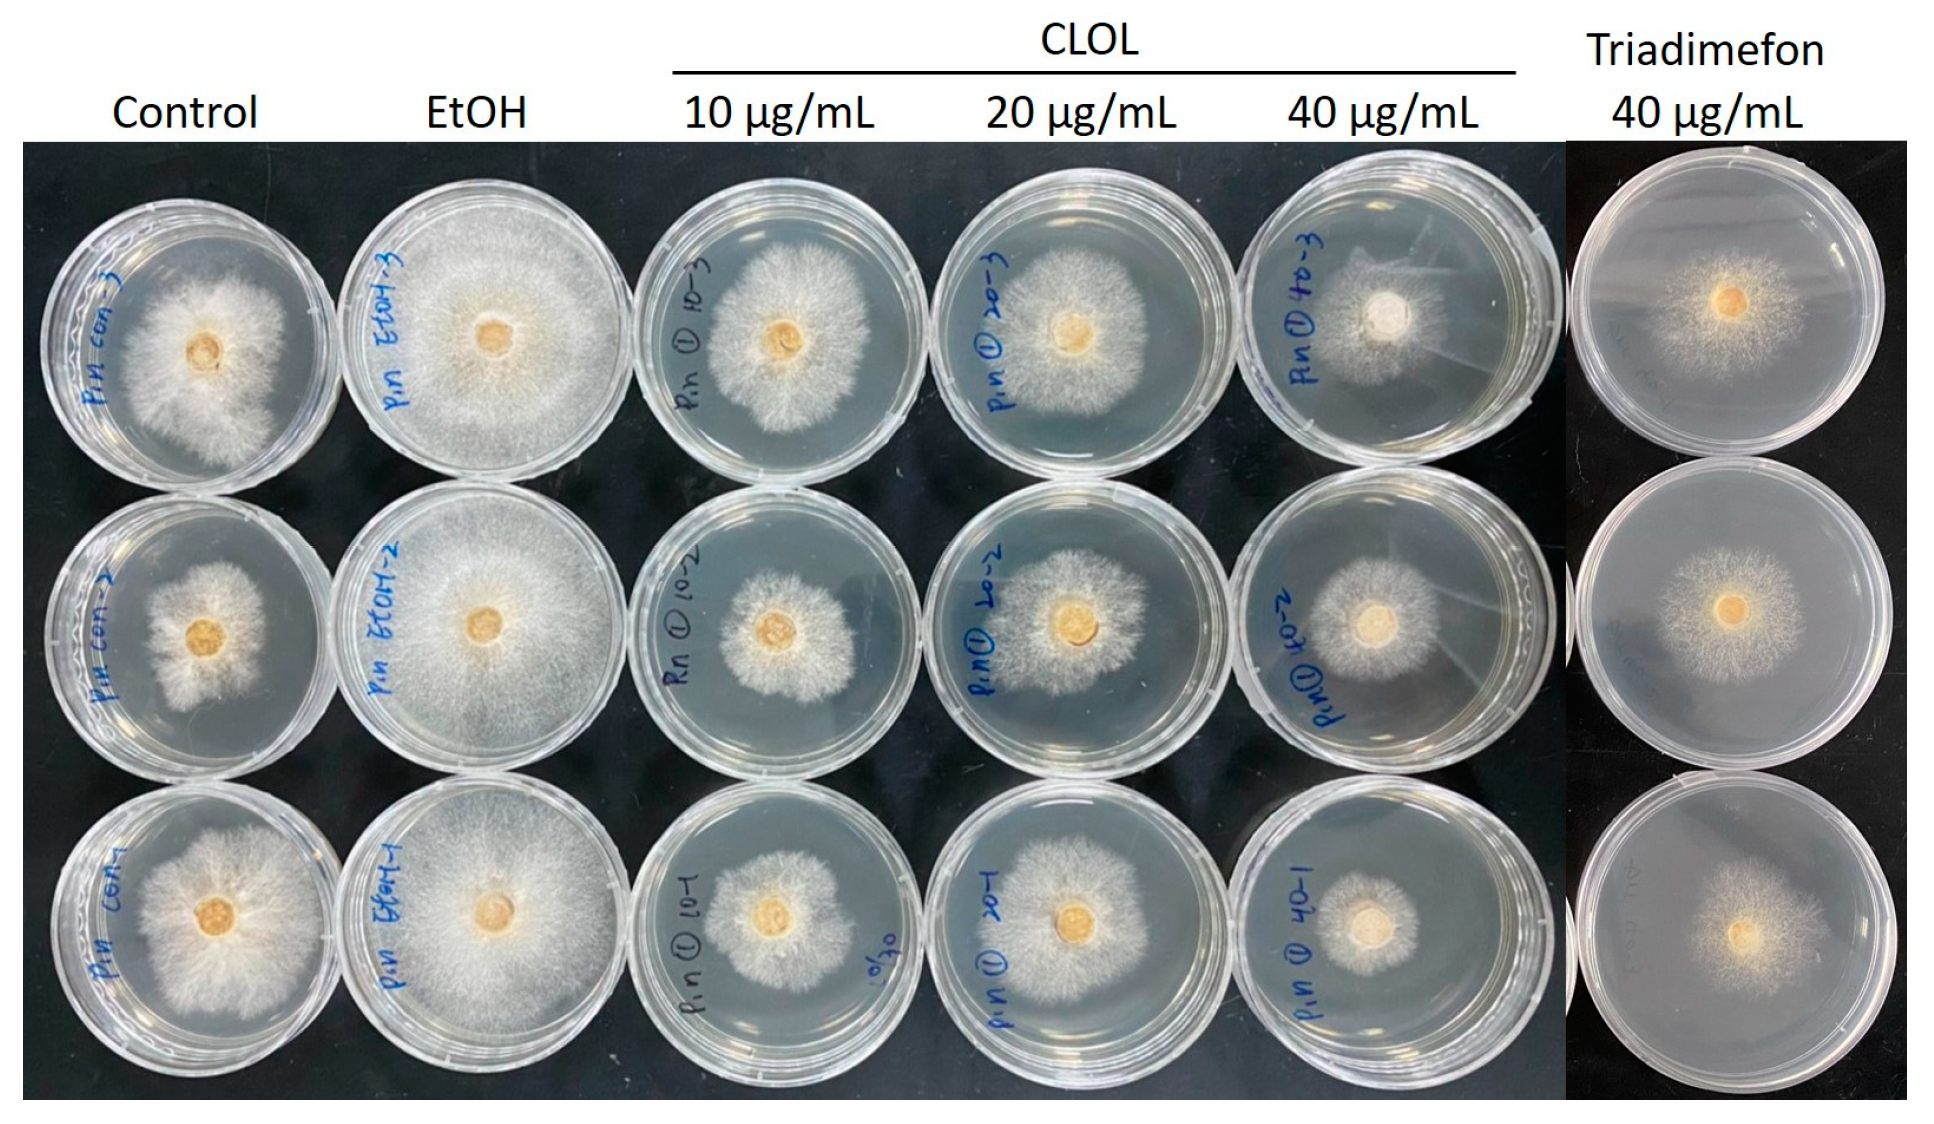

Antifungal Activity of Cedrol from Cunninghamia lanceolate var. konishii against Phellinus noxius and Its Mechanism
Abstract
1. Introduction
2. Results and Discussion
2.1. Comparing the Antifungal Activity of Taiwan’s Five Precious Woods
2.2. Composition Analysis of CLOL and Evaluation of Its Potent Antifungal Activity Compounds
2.3. The Impact of Cedrol on the Morphology of P. noxius Hyphae
2.4. Cedrol Induces Oxidative Stress on P. noxius
2.5. Cedrol induces damage to P. noxius Genomic DNA (gDNA)
2.6. Cedrol Induces Apoptosis in P. noxius
2.7. Cedrol Reduces the Mitochondrial Membrane Potential of P. noxius
2.8. Pathway of Cedrol-Induced Apoptosis in P. noxius
3. Materials and Methods
3.1. Preparation Essential Oil from Cunninghamia lanceolate var. konishii Wood and Its Composition Analysis
3.2. Antifungal Assay
3.3. Examining Fungal Hyphal Growth through Scanning Electron Microscopy (SEM)
3.4. DCFH-DA Fluorescence Staining
3.5. DNA Electrophoresis
3.6. TUNEL Staining
3.7. Mitochondrial Membrane Potential Analysis
3.8. Protein Expression Analysis
3.9. Statistical Analysis
4. Conclusions
Supplementary Materials
Author Contributions
Funding
Data Availability Statement
Conflicts of Interest
References
- Chung, C.L.; Huang, S.Y.; Huang, Y.C.; Tzean, S.S.; Ann, P.J.; Tsai, J.N.; Yang, C.C.; Lee, H.H.; Huang, T.W.; Huang, H.Y.; et al. The genetic structure of Phellinus noxius and dissemination pattern of brown root rot disease in Taiwan. PLoS ONE 2015, 10, e0139445. [Google Scholar] [CrossRef] [PubMed]
- Wu, J.; Peng, S.L.; Zhao, H.B.; Tang, M.H.; Li, F.R.; Chen, B.M. Selection of species resistant to the wood rot fungus Phellinus noxius. Eur. J. Plant Pathol. 2011, 130, 463–467. [Google Scholar] [CrossRef]
- Ann, P.J.; Chang, T.T.; Ko, W.H. Phellinus noxius brown root rot of fruit and ornamental trees in Taiwan. Plant Dis. 2002, 86, 820–826. [Google Scholar] [CrossRef] [PubMed]
- Chang, T.T. Decline of some forest trees associated with brown root rot caused by Phellinus noxius. Plant Pathol. Bull. 1995, 1, 90–95. [Google Scholar]
- Delattin, N.; Cammue, B.P.; Thevissen, K. Reactive oxygen species-inducing antifungal agents and their activity against fungal biofilms. Future Med. Chem. 2014, 6, 77–90. [Google Scholar] [CrossRef] [PubMed]
- Cheng, S.S.; Lin, C.Y.; Chen, Y.J.; Chung, M.J.; Chang, S.T. Insecticidal activities of Cunninghamia konishii Hayata against Formosan subterranean termite, Coptotermes formosanus (Isoptera: Rhinotermitidae). Pest Manag. Sci. 2014, 70, 1215–1219. [Google Scholar] [CrossRef]
- Cheng, S.S.; Chung, M.J.; Lin, C.Y.; Wang, Y.N.; Chang, S.T. Phytochemicals from Cunninghamia konishii Hayata act as antifungal agents. J. Agric. Food Chem. 2012, 60, 124–128. [Google Scholar] [CrossRef]
- Ho, C.L.; Hua, K.F.; Hsu, K.P.; Wang, E.I.; Su, Y.C. Composition and antipathogenic activities of the twig essential oil of Chamaecyparis formosensis from Taiwan. Nat. Prod. Commun. 2012, 7, 933–936. [Google Scholar] [CrossRef]
- Chang, S.T.; Wang, D.S.Y.; Wu, C.L.; Shiah, S.G.; Kuo, Y.H.; Chang, C.J. Cytotoxicity of extractives from Taiwania cryptomerioides heartwood. Phytochemistry 2000, 55, 227–232. [Google Scholar] [CrossRef]
- Shyur, L.F.; Lee, S.H.; Chang, S.T.; Lo, C.P.; Kuo, Y.H.; Wang, S.Y. Taiwanin A inhibits MCF-7 cancer cell activity through induction of oxidative stress, upregulation of DNA damage checkpoint kinases, and activation of p53 and FasL/Fas signaling pathways. Phytomedicine 2010, 18, 16–24. [Google Scholar] [CrossRef]
- Chang, S.T.; Cheng, S.S.; Wang, S.Y. Antitermitic activity of essential oils and components from Taiwania (Taiwania cryptomerioides). J. Chem. Ecol. 2001, 27, 717–724. [Google Scholar] [CrossRef] [PubMed]
- Chen, Y.H.; Lin, C.Y.; Yen, P.L.; Yeh, T.F.; Cheng, S.S.; Chang, S.T. Antifungal agents from heartwood extract of Taiwania cryptomerioides against brown root rot fungus Phellinus noxius. Wood Sci. Technol. 2017, 51, 639–651. [Google Scholar] [CrossRef]
- Cheng, S.S.; Lin, C.Y.; Chung, M.J.; Chen, Y.J.; Chang, S.T. Potential source of environmentally benign antifungal agents from Cinnamomum osmophloeum leaves against Phellinus noxius. Plant Prot. Sci. 2019, 55, 43–53. [Google Scholar] [CrossRef]
- Bartikova, H.; Hanusova, V.; Skalova, L.; Ambroz, M.; Bousova, I. Antioxidant, pro-oxidant and other biological activities of sesquiterpenes. Curr. Top. Med. Chem. 2014, 14, 2478–2494. [Google Scholar] [CrossRef] [PubMed]
- Mittler, R. ROS Are Good. Trends Plant Sci. 2017, 22, 11–19. [Google Scholar] [CrossRef]
- Maurya, I.K.; Pathak, S.; Sharma, M.; Sanwal, H.; Chaudhary, P.; Tupe, S.; Deshpande, M.; Chauhan, V.S.; Prasad, R. Antifungal activity of novel synthetic peptides by accumulation of reactive oxygen species (ROS) and disruption of cell wall against Candida albicans. Peptides 2011, 32, 1732–4170. [Google Scholar] [CrossRef] [PubMed]
- Lupetti, A.; Paulusma-Annema, A.; Senesi, S.; Campa, M.; Van Dissel, J.T.; Nibbering, P.H. Internal thiols and reactive oxygen species in candidacidal activity exerted by an N-terminal peptide of human lactoferrin. Antimicrob. Agents Chemother. 2002, 46, 1634–1639. [Google Scholar] [CrossRef]
- Hwang, B.; Hwang, J.S.; Lee, J.; Lee, D.G. The antimicrobial peptide, psacotheasin induces reactive oxygen species and triggers apoptosis in Candida albicans. Biochem. Biophys. Res. Commun. 2011, 405, 267–271. [Google Scholar] [CrossRef]
- Yadav, A.K.; Sirohi, P.; Saraswat, S.; Rani, M.; Singh, M.P.; Srivastava, S.; Singh, N.K. Inhibitory Mechanism on combination of phytic acid with methanolic seed extract of Syzygium cumini and sodium chloride over Bacillus subtilis. Curr. Microbiol. 2018, 75, 849–856. [Google Scholar] [CrossRef]
- Lowary, P.T.; Widom, J. Higher-order structure of Saccharomyces cerevisiae chromatin. Proc. Natl. Acad. Sci. USA 1989, 86, 8266–8270. [Google Scholar] [CrossRef]
- Mousavi, S.A.A.; Robson, G.D. Entry into the stationary phase is associated with a rapid loss of viability and an apoptotic-like phenotype in the opportunistic pathogen Aspergillus fumigatus. Fungal Genet. Biol. 2003, 39, 221–229. [Google Scholar] [CrossRef] [PubMed]
- Madeo, F.; Herker, E.; Wissing, S.; Jungwirth, H.; Eisenberg, T.; Fröhlich, K.U. Apoptosis in yeast. Curr. Opin. Microbiol. 2004, 7, 655–660. [Google Scholar] [CrossRef] [PubMed]
- Jing, H.; Liu, H.; Zhang, L.; Gao, J.; Song, H.; Tan, X. Ethanol Induces Autophagy Regulated by Mitochondrial ROS in Saccharomyces cerevisiae. J. Microbiol. Biotechnol. 2018, 8, 1982–1991. [Google Scholar] [CrossRef] [PubMed]
- Adamczyk, J.; Deregowska, A.; Skoneczny, M.; Skoneczna, A.; Kwiatkowska, A.; Potocki, L.; Rawska, E.; Pabian, S.; Kaplan, J.; Lewinska, A.; et al. Adaptive response to chronic mild ethanol stress involves ROS, sirtuins and changes in chromosome dosage in wine yeasts. Oncotarget 2016, 7, 29958–29976. [Google Scholar] [CrossRef]
- Ludovico, P.; Rodrigues, F.; Almeida, A.; Silva, M.T.; Barrientos, A.; Corte-Real, M. Cytochrome c release and mitochondria involvement in programmed cell death induced by acetic acid in Saccharomyces cerevisiae. Mol. Biol. Cell 2003, 13, 2598–2606. [Google Scholar] [CrossRef]
- Wissing, S.; Ludovico, P.; Herker, E.; Büttner, S.; Engelhardt, S.M.; Decker, T.; Link, A.; Proksch, A.; Rodrigues, F.; Corte-Real, M.; et al. An AIF orthologue regulates apoptosis in yeast. J. Cell Biol. 2004, 166, 969–974. [Google Scholar] [CrossRef]
- Saxena, M.; Sharma, R.K.; Ramirez-Paz, J.; Tinoco, A.D.; Griebenow, K. Purification and characterization of a cytochrome c with novel caspase-3 activation activity from the pathogenic fungus Rhizopus arrhizus. BMC Biochem. 2015, 16, 21. [Google Scholar]

| µg/mL | CL | TC | CM | CF | CO |
|---|---|---|---|---|---|
| 50 | 57.7% | 53.8% | 35.8% | 48.5% | 15.4% |
| 100 | 69.2% | 65.4% | 67.7% | 72.3% | 11.5% |
| 200 | 76.9% | 76.9% | 100% | 100% | 26.9% |
| 400 | 80.8% | 80.8% | 100% | 100% | 61.5% |
| IC50 | <50 | <50 | 72.3 | 53.2 | 335.4 |
| RT | KI | Concentration% | Constituent | Identification |
|---|---|---|---|---|
| 21.16 | 1191 | 0.70 | α-Terpineol | KI/MS/ST |
| 31.12 | 1410 | 8.66 | α-Cedrene | KI/MS/ST |
| 31.44 | 1418 | 2.46 | β-Cedrene | KI/MS/ST |
| 31.91 | 1430 | 0.38 | cis-Thujopsene | KI/MS |
| 34.91 | 1501 | 0.36 | Cuparene | KI/MS/ST |
| 35.04 | 1504 | 0.43 | α-Chamigrene | KI/MS/ST |
| 38.39 | 1589 | 1.06 | Globulol | KI/MS |
| 38.97 | 1604 | 78.48 | Cedrol | KI/MS/ST |
| 39.40 | 1617 | 1.05 | epi-Cedrol | KI/MS/ST |
| 39.75 | 1627 | 1.59 | γ-Eudesmol | KI/MS/ST |
| 40.61 | 1651 | 2.87 | α-Cadinol | KI/MS/ST |
| Total | 98.04 |
| Concentration (µg/mL) | CL Wood Essential Oils | Cedrol |
|---|---|---|
| 10 | 39.1% | 45.4% |
| 20 | 34.0% | 50.3% |
| 40 | 52.6% | 90.2% |
| IC50 | 37.5 | 15.7 |
Disclaimer/Publisher’s Note: The statements, opinions and data contained in all publications are solely those of the individual author(s) and contributor(s) and not of MDPI and/or the editor(s). MDPI and/or the editor(s) disclaim responsibility for any injury to people or property resulting from any ideas, methods, instructions or products referred to in the content. |
© 2024 by the authors. Licensee MDPI, Basel, Switzerland. This article is an open access article distributed under the terms and conditions of the Creative Commons Attribution (CC BY) license (https://creativecommons.org/licenses/by/4.0/).
Share and Cite
Hsiao, W.-W.; Lau, K.-M.; Chien, S.-C.; Chu, F.-H.; Chung, W.-H.; Wang, S.-Y. Antifungal Activity of Cedrol from Cunninghamia lanceolate var. konishii against Phellinus noxius and Its Mechanism. Plants 2024, 13, 321. https://doi.org/10.3390/plants13020321
Hsiao W-W, Lau K-M, Chien S-C, Chu F-H, Chung W-H, Wang S-Y. Antifungal Activity of Cedrol from Cunninghamia lanceolate var. konishii against Phellinus noxius and Its Mechanism. Plants. 2024; 13(2):321. https://doi.org/10.3390/plants13020321
Chicago/Turabian StyleHsiao, Wen-Wei, Ka-Man Lau, Shih-Chang Chien, Fang-Hua Chu, Wen-Hsin Chung, and Sheng-Yang Wang. 2024. "Antifungal Activity of Cedrol from Cunninghamia lanceolate var. konishii against Phellinus noxius and Its Mechanism" Plants 13, no. 2: 321. https://doi.org/10.3390/plants13020321
APA StyleHsiao, W.-W., Lau, K.-M., Chien, S.-C., Chu, F.-H., Chung, W.-H., & Wang, S.-Y. (2024). Antifungal Activity of Cedrol from Cunninghamia lanceolate var. konishii against Phellinus noxius and Its Mechanism. Plants, 13(2), 321. https://doi.org/10.3390/plants13020321

